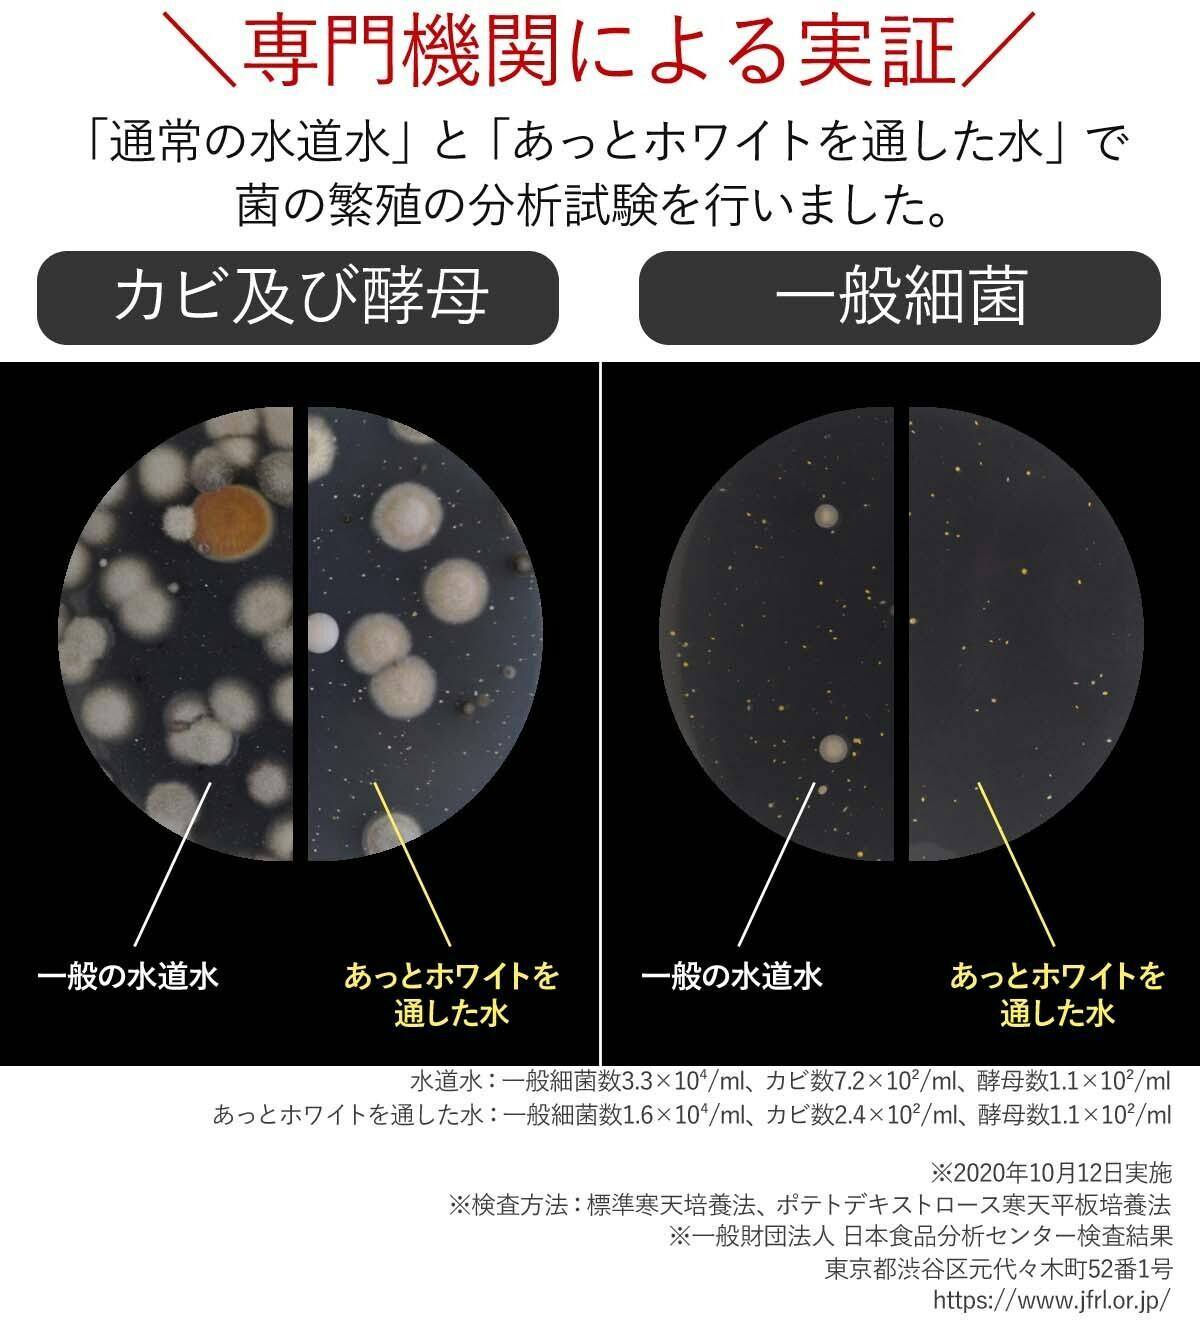

machi-yaをご覧の皆様、こんにちは!
株式会社ドリームバンクと申します。
冬は部屋干しの機会が増えますね。今回開発に至りましたのが洗濯機用アダプター
「あっとホワイト洗濯機用」です。
こんなお困りごとはありませんか?

寒い時期は部屋干ししたいけど、生乾きのニオイにガッカリ、、、。
そんなあなたに毎日のお洗濯が「うんざり」から「わくわく」に変わるアイテムの
ご提案です。



実際に洗ってみました!

専門機関による検証
溶解油分とは、「洗い流せた汚れ」のことです。
だから、溶解油分値は高ければ高いほど、たしかな洗浄力の証明となります。
他の汚れでも検証してみました!

落ちにくい汚れもありましたが、
洗剤不使用でここまで汚れを落とすことができました。
洗濯物だけじゃない!
あっとホワイトで洗い続けると・・・?結果はのちほど!


ナノバブルには、「洗剤の洗浄成分(界面活性作用)」の効果があります。
衣類の繊維の奥までバブルが侵入し、
汚れを根元から落としやすくするチカラがあります。



くるくる回すだけの超簡単作業でお取り付けいただくことができます。
※実際にお取り付ける際は、万全の安全を期して、
念のため軍手をはめて作業を行ってください。

あっとホワイトの新機能!!


さらに!!


ごみが溜まったら簡単お手入れ!

つまようじでメッシュを取り外して、いつでも手軽にお手入れや水洗いが可能です。
さらに、メッシュが2枚あることで、洗濯の待ち時間にメッシュのお手入れができ、
待ち時間を有効活用することができます!
メッシュが不要の方は、取り外してご使用いただくこともできます!

衛生面を考慮し、逆流汚れ防止機能も搭載。
汚れた洗濯水と生成された新鮮なバブルの混合を防ぎ、
毎日クリーンな環境で使用できる構造に設計しました。

あっとホワイトから発生するナノバブルの防菌効果により、
洗濯で衣類をより清潔に保つ効果が期待できます。


調査の結果、生乾き・部屋干しのニオイが気になる方が多いようです。
そんな洗濯のお悩みも“あっとホワイトたった1つ”で洗い流します。


「いつも通り洗濯機を使うだけ!」
POINT2で紹介した続きです。あっとホワイトから生成されるナノバブルは
洗濯物だけでなく、お手入れの面倒な洗濯槽までキレイにするチカラがあるのです。
ニオイの原因でもある洗濯槽のカビや汚れがキレイになれば気分が上がりますよね!


写真はあっとホワイトの製造背景です。
岐阜県の国内工場クリーンルームにて徹底管理を行いながら、
職人が一つ一つ丁寧に心を込めて組立てを行っております。



網目ローレットのついた3メートルの棒のローレット部分を少し残し切削していきます。
3メートルの棒1本からは65個のあっとホワイトが作り出されます。
※写真はメッキ前の状態です。

削りで出た粉は切り落とした後に洗浄をしてキレイに洗い流します。

3メートルの棒からあっとホワイトが1つ制作されるまでにかかる時間は3分40秒です。
この後にメッキ加工と逆止弁の埋め込みをします。

メッキ処理が終わると、クリーンな部屋で職人さんが一つ一つ丁寧に
逆流防止弁の埋め込みをし、梱包をしていきます。




※保証期間は製品がご到着した日をもって保証期間開始日とさせていただきます。
※保証期間内であっても、使用上の誤り・不当な修理・パッキンなど消耗品の劣化等
による故障・破損・損傷は保証対象外となりますのでご了承ください。

Q.取り付けられない洗濯機はありますか。
A.二層式の洗濯機にはお取り付けできません。
縦型やドラム式(ネジ径はG3/4)の一般的な洗濯機にはお取り付けいただけます。
(※なお、ネジ径は全自動洗濯機であれば全国共通です。)
Q.洗剤や柔軟剤は、通常通り使いますか。
A.はい。通常通りご使用ください。
Q.残り湯を汲むホースは装着できますか。
A.いいえ。申し訳ございませんが、本商品は給水栓に取り付けることを前提に
設計しておりますので、残り湯を給水するホースにはお使いいただけません。
残り湯を使うのであれば、すすぎで必ず給水栓を使用する洗濯機でしたら、
すすぎの際には利用できます。


株式会社ドリームバンクと申します。私どもは、清流の町岐阜県富加町に本社を
かまえる、浄水器メーカーでございます。据置型浄水器を中心に、アンダーシンク、
セントラルなど 、おもに浄水器関連の製品を開発・製造しております。
長年の浄水器・水処理装置開発の経験を活かし、水に関わる新しい商品を
開発できないかを考えてまいりました。
実は、以前から楽天・ヤフーなどのECサイトにてあっとホワイトの父とも呼べる
洗濯機用のあっとホワイトを販売しており、
多くの方に手に取っていただいております。ありがとうございます。
そして今回開発に至りましたのが「あっとホワイト洗濯機用」の改良版です。
見た目に変化はございませんが、製品の内部にゴミ取り用のメッシュを加えることで
水道水に含まれている小さなゴミが洗濯機内に侵入するのを防ぐことができます。
お客様からいただいたお声をもとに、あると嬉しい機能を追加した製品でございます。


ドリームバンクでは、SDGs(持続可能な開発目標)の目標達成に向けた取り組みを
実施しております。
そして今回のプロジェクトの対象となります目標は、
持続可能な開発目標(SDGs)目標12『つくる責任・つかう責任』です。
当商品は、本体内部の特殊構造により、
ナノバブルを生成し洗浄力を向上させる商品です。
洗浄力を高めることで洗剤の使い過ぎを抑え、水環境への負荷を減らします。
また、繰り返し使える製品なので、洗剤の容器のごみの排出も抑えます。
その他、梱包印刷の撤廃や梱包の簡易化にも力を注いでおります。

洗濯機やホースの中を清潔に保てるようにするにはどうすればよいか?
コストをかけずに安価に提供するには?
何度も試行錯誤し、メッシュを取り入れることで安価に高品質な製品をお届けできると
決断に至りました。
最後までお読みいただきありがとうございました。
ぜひ気に入っていただけましたら幸いです。

特定商取引法に関する記載
◯ 販売事業者名: 株式会社ドリームバンク
◯ 代表者名:才藤清司
◯ 事業者の所在地:〒501-3303 岐阜県加茂郡富加町羽生2426番地2
◯ 事業者の連絡先:TEL 0574-49-6061
※こちらでは当該製品に対するお申し込み、質問等は受け付けておりません。
◯ リターン価格:各リターン記載の通り
◯リターン価格:各リターン記載の通り *商品内容についてはリターン欄記載の通り
※リターン価格とは別にCAMPFIRE(machi-ya)のシステム利用料として、支援金額1万円未満の場合は250円(税込)/ 1万円以上の場合は支援額の2.5%(税込)
が支援者様の負担となります。
※上記システム利用料はCAMPFIREが受け取るもので、当社が受領するものではございません。
※手数料改定に関する詳細はこちら (https://help.camp-fire.jp/hc/ja/articles/230679948)
◯送料:送料込み
◯対価以外に必要な費用:プロジェクトページ、リターンに記載のとおり。
◯支払い方法:CAMPFIREの決済手段に準ずる (詳細はこちら)
◯支払い時期:当プロジェクトは「All-in型」の為、目標達成の如何に問わず、ご契約が成立しリターンをお届けします。
その為、お申込みと同時にご利用の決済方法に準じてご請求となります。
◯引渡し時期: 各リターン詳細に記載の発送予定月を引き渡し時期とします。
但し、開発・生産状況によって遅れが生じる場合がありますのでその際は当プロジェクトページ内の「活動報告」または購入者へのメール等で連絡します。
◯キャンセル・返品: 当プロジェクトは「All-in型」の為、お申込み完了をもって契約が成立いたします。その為、お客様都合による返品・キャンセルはできませんのでご注意ください。
尚、製品到着後に破損や初期不良がある場合には交換させていただきますので「メッセージで意見や問い合わせを送る」から、または納品書記載の連絡先までお問い合わせください。
◯ソフトウェアに係る取引である場合のソフトウェアの動作環境:該当なし
◯その他記載事項:プロジェクトページ、リターン記載欄、共通記載欄(https://camp-fire.jp/legal)をご確認ください。
最新の活動報告
もっと見る出荷完了のお知らせ
2023/02/21 14:06お世話になっております。株式会社ドリームバンクです。ご支援くださったサポーターのみなさま、この度はありがとうございました。当製品につきまして、2/17に出荷完了いたしましたのでご報告させていただきます。ご到着まで、今しばらくお待ちくださいませ。この度は応援購入をいただきまして誠にありがとうございます。どうぞよろしくお願い申し上げます。 もっと見る完売のお礼
2023/01/11 15:07CAMPFIREをご覧の皆様、こんにちは。株式会社ドリームバンクです。この度は当プロジェクトにご支援をいただき誠にありがとうございます。プロジェクト開始から1ヵ月も経たずリターンが全て完売となりました。予想を超える反響をいただき私たちとしても嬉しく思っております。多くのご支援をいただき、感謝の気持ちでいっぱいです。当製品の配送につきましては、またご報告させていただきますので、ご確認いただけますと幸いです。よろしくお願いいたします。 もっと見る
【機能紹介】部屋干しの嫌なニオイもスッキリ!
2022/12/22 16:03CAMPFIREをご覧の皆様、こんにちは。株式会社ドリームバンクです。この度は皆様からたくさんのご支援をいただき、感謝の気持ちでいっぱいです。冬は部屋干しの機会が増えますね。部屋干しの嫌なニオイなど気になりませんか?『あっとホワイト』から発生するナノバブルには、ニオイの原因となる細菌への防菌効果が期待されます。部屋干しをするときの「うんざり」から「わくわく」に変わるアイテムをぜひ体験してみてください。これだけではありませんが、他の機能も今後紹介していきますので、ぜひ一度ページをご覧いただけますと幸いです。以上、引き続き当プロジェクトをよろしくお願いいたします。 もっと見る





コメント
もっと見る